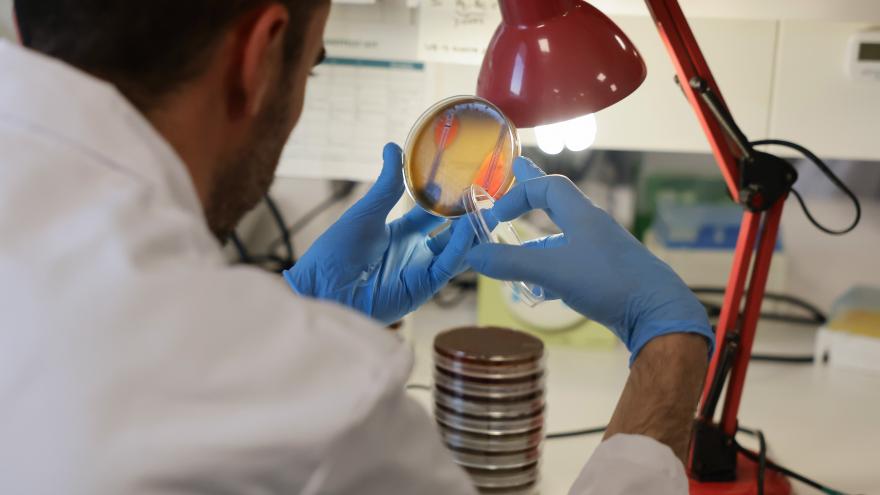

La Comunidad de Madrid avanza en la incorporación de nuevas prestaciones asistenciales al Hospital público Enfermera Isabel Zendal
La Comunidad de Madrid avanza en la incorporación de nuevas prestaciones asistenciales al Hospital público Enfermera Isabel Zendal. Construido en tiempo récord en 2020 durante la primera ola de la pandemia por COVID-19, y después de haber sido referente mundial en el tratamiento a estos pacientes, ahora es pionero en la atención a las personas con Esclerosis Lateral Amiotrófica (ELA), gracias a su Centro de Diurno especializado en esta patología que se estrenó en abril del año pasado.

También en 2025 abrirá su Centro de Neurorrehabilitación Funcional, destinado a la recuperación del daño neurológico en niños y adultos, así como a la hospitalización de lesionados medulares, y contará con la tecnología más avanzada en este campo de actividad.
En estas actuaciones el Gobierno regional va a invertir 11 millones de euros, que servirán además para la puesta en marcha del Instituto Experimental de Neurotecnología de Salud del Cerebro, que entrará en funcionamiento este próximo año, un paso más en la mejora de la salud cerebral profundizando en la investigación y el progreso científico de enfermedades neurodegenerativas de tanto impacto como la demencia, el Parkinson o el Alzheimer.
Así, el pabellón 3 del Zendal gozará de dispositivos de vanguardia para el diagnóstico médico de patologías neurodegenerativas, entre ellos resonancias magnéticas de alto campo que optimicen su análisis y detección precoz, así como recursos de ingeniería biomédica e Inteligencia Artificial, que mejorarán la calidad asistencial y de vida de los pacientes.
La cartera de servicios se completará con un Centro de Diagnóstico y Tratamiento de Alta Resolución, con espacios adecuados y equipos de última generación para pruebas de laboratorio, radiografías, ecografías, tomografías computerizadas (TAC) y resonancias magnéticas abiertas.
Emergencias sanitarias y catástrofes
Casi cinco años después del comienzo de la pandemia, el Hospital Enfermera Isabel Zendal se mantiene como una infraestructura única de la sanidad pública madrileña para la atención de emergencias o catástrofes en caso de necesidad.
Así, en su pabellón 2 están dispuestas, de manera permanente, las unidades de Cuidados Intensivos (UCI) y de Cuidados Respiratorios Intermedios (UCRI), al igual que un espacio de hospitalización convencional con capacidad para asistir grandes demandas en menos de 48 horas.
Casi cinco años de historia
Con casi cinco años de historia, el Zendal nació en 2020 como continuación del dispositivo asistencial de emergencias habilitado por la Comunidad de Madrid en IFEMA, y tuvo unos excelentes resultados. Se edificó en un tiempo record, entre julio y noviembre de ese mismo año, para entrar en funcionamiento el 1 de diciembre, atendiendo de manera inmediata a sus primeros pacientes.
Su objetivo era dotar a la sanidad pública madrileña de la suficiente capacidad para aliviar al sistema hospitalario madrileño de potenciales presiones asistenciales en momentos de pandemia u otras emergencias sanitarias, como así ocurrió.
Registró 9.881 ingresos con COVID: 8.918 en 2021 y 963 en 2022, siendo capaz de absorber el 30% de todos los enfermos que cumplían con los criterios de ingreso, estabilidad y cuidados, demostrando la eficacia e idoneidad de contar con este recurso.
Después de casi 500 días de actividad luchando por la vida, el Zendal comenzó una nueva etapa. A partir de abril de 2022 se convirtió en un centro de media estancia con una Unidad de Recuperación Funcional (URF) para la rehabilitación motora de los pacientes, con servicios de Logopedia, Terapia Ocupacional y Psicológica, y de cuidados de continuidad en régimen de hospitalización o ambulatorios, contabilizando hasta un total de 969 ingresos.
También ha servido desde sus inicios como centro de vacunación, con 2.265.998 dosis inoculadas contra el COVID, 3.019 de gripe y 361 de viruela del mono (MPOX). Además, se habilitó como recurso para la recepción y atención a refugiados ucranianos desde la invasión rusa en febrero de 2022.